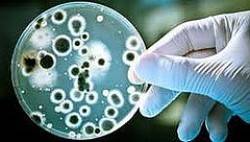
Mentioning the Name of Allah During Slaughter Keeps Meat  Completely Free from Germs

The meat of an animal that is slaughtered by mentioning Bismillaah ("In the Name of Allah") and Takbeer ("Allahu Akbar") is completely free of all disease-causing germs, while the meat that does not have the Name of Allah mentioned when it is slaughtered is full of germs and congested with blood.
A team of researchers and university professors in Syria made this scientific discovery that explains the remarkable difference regarding the absence of germs in meat that is slaughtered with Takbeer, in comparison to the meat that does not have Takbeer mentioned when it is slaughtered.
A group of 30 specialists in different branches of medicine such as laboratory medicine, pathology, food sciences, anatomical pathology, animal health, digestive diseases and the digestive system conducted laboratory experiments over a period of three years to study the difference between animals slaughtered with mentioning the Name of Allah and the animals slaughtered without mentioning the Name of Allah upon them.
The research affirmed the importance of mentioning the Name of Allah (Bismillaah and Allahu Akbar) on the animal at the time of slaughter. Dr. Khaalid Halaawah, spokesman for this group of researchers, explains that repeated tests showed that the tissues of the animals that did not have the Name of Allah and Takbeer mentioned at their slaughter were congested with blood, and full of colonies of pathogens (disease-causing microorganisms).
On the other hand, the meat of the animal that had been slaughtered with the mention of Bismillaah and Allahu Akbar was free of germs and completely drained of all blood.
In his interview with Kuna News Agency, Dr. Halaawah added that this great discovery is a scientific breakthrough in the field of the consumer health and safety.
Another member of the team of researchers, Professor ‘Abdul-Qaadir Al-Deeraani said,
“People have not yet realized the wisdom behind mentioning the Name of Allah on the slaughtered animal. Consequently, they neglect and leave off pronouncing the Name of Allah and Takbeer when the cattle and birds are slaughtered. This, however, made me introduce this issue with an academic and scientific approach, showing its importance and significance for human society. I based this study upon the explanation of the eminent scholar Muhammad Ameen Sheekho in his Quranic teachings and lessons, that the animal that is slaughtered without mentioning the Name of Allah on it will have blood remaining therein and cannot be in any way free from germs.”
It is worth mentioning here that Allah The Almighty has commanded mentioning Bismillaah when slaughtering animals. Allah The Almighty Says (what means):
- {So eat of that [meat] upon which the Name of Allah has been mentioned, if you are believers in His verses.} [Quran 6:118]
- {And do not eat of that upon which the Name of Allah has not been mentioned, for indeed, it is grave disobedience…..} [Quran 6: 121]
- {…And those upon which the Name of Allah is not mentioned….} [Quran 6:138]
Professor ‘Abdul-Qaadir Ad-Deeraani said that at the outset of the study, the research team took the matter of pronouncing Bismillaah and Takbeer lightly and doubted it; however, they were amazed with the first results and paid close attention to it thereafter. The team discovered that mentioning the Name of Allah has an amazing, some might even say 'miraculous' effect, through the absence of all kinds of germs from the meat on which the Name of Allah was mentioned during the slaughter. Their tissues were free of blood. On the contrary, the meat on which the Name of Allah was not mentioned during the slaughter was full of blood and colonies of pathogens.
Regarding the research methodology adopted by the medical team, Dr. Nabeel Ash-Shareef, ex-dean of the Faculty of Pharmacy, at Damascus University, said that microbiological studies were conducted on many samples of bird, cow and sheep meat on which the Name of Allah was loudly recited during the slaughter and that on which the Name of Allah was not mentioned at the time of slaughter. He added that the samples were soaked in 10% Dettol solution. An hour later, a piece of meat was taken from each sample and cultured in Neoglucol cultivated solution.
He added that 24 hours following the incubation in a dry heating device at a temperature of 37 Centigrade, suitable parts were transferred to the following solid cultures: Nutritive Agar, Blood base Agar, and EMB. They were then left in the heating device for 48 hours.
He continued that a change in color was noticed between the two different samples: the first sample on which the Name of Allah was mentioned was rose-colored, whereas the second, on which the Name of Allah was not mentioned was dark bluish- red.
Dr. Ash-Shareef said that the samples were studied microbiologically and the following was observed: the samples on which the Name of Allah was mentioned loudly did not show any germ growth. Neoglucol appeared to be clear and free of germs and viruses. On the samples on which the Name of Allah was not mentioned, Neoglucol appeared to be very turbid indicating a large growth of germs.
Dr. Ash-Shareef added that after 48 hours of transferring the above- mentioned surroundings, the following results appeared: There was a large growth of streptococcus and staphylococcus colonies. The EMB helps to grow Gram negative bacteria like Bacilli and E. Coli bacilli, as well as an intensive growth of germs was detected in the Nutritive Agar.
Dr. Ash-Shareef said that a larger number of white blood corpuscles were noticed in the muscular tissue, and a larger number of red-blood corpuscles in the blood vessels in the samples on which the Name of Allah was not recited, whereas, the tissue of meat on which the Name of Allah was recited were almost free of these blood corpuscles.
Dr. Fu’aad Ni‘mah, professor of veterinary medicine, said that the vigorous movements of the animal's organs and muscles produced by mentioning the Name of Allah during the slaughter ensures the outflow of the greatest amount of blood from the slaughtered animal. When the Name of Allah is not mentioned during slaughter, a large amount of this blood stays in its body and this allows many disease-causing germs that are already present in it to grow and increase in number. If the consumer eats this meat, these pathogens would penetrate the mucous membrane of the stomach and enter all the organs of the body through the bloodstream, causing various diseases like food poisoning, toxicosis and inflammation of the cardiac muscles.
Professor Daarim Tabaa‘i, general health specialist and head of the Animal Protection Project in Syria, mentioned in some countries were killed (i.e. slaughtered) using harmful methods such as suffocation by gas, electric shock or by shooting. These methods allow the blood to remain in the body of the animal, making it a conducive environment for the growth of various pathogens. These methods also cause the animal greater suffering and pain, which is reflected in the color of meat, which becomes bluish. On the other hand, mentioning the Name of Allah at the time of slaughter causes minimal suffering.


 Home
Home Discover Islam
Discover Islam Quran Recitations
Quran Recitations Lectures
Lectures
 Fatwa
Fatwa Articles
Articles Fiqh
Fiqh E-Books
E-Books Boys & Girls
Boys & Girls  Articles
Articles